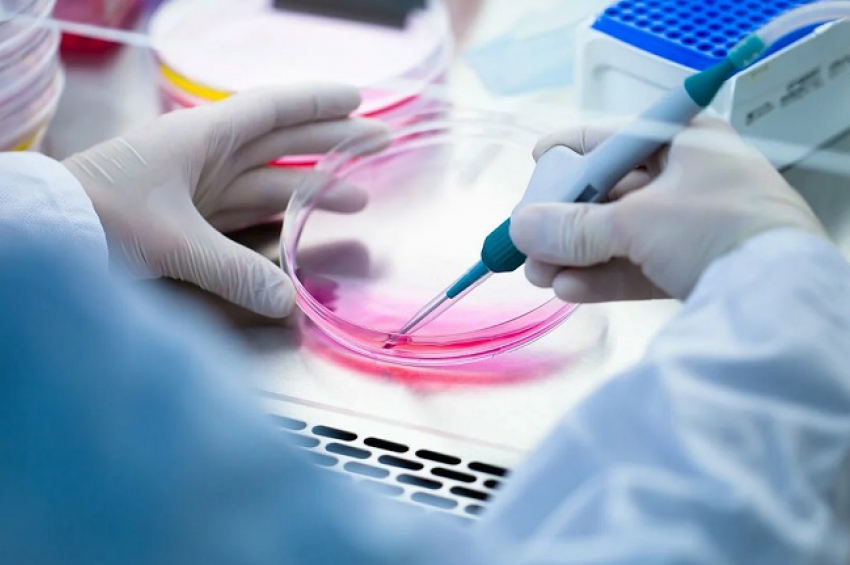

Здравен портал
Разработиха тест за нивото на антитела срещу разновидностите на COVID-19
Разработиха тест за нивото на антитела срещу разновидностите на COVID-19
Учени от Канада и САЩ разработиха тест, чрез който може да се проследи нивото на антителата срещу различните варианти на вируса SARS-CoV-2, причиняващ Ковид-19, съобщи NOVA, позовавайки се на електронното издание Юрикалърт. Специалистите са установили, че антителата на хората, които са ваксинирани и/или са преболедували от инфекцията преди 2022 г. не успяват да неутрализират циркулиращите в момента разновидности.
"Истината е, че все още не знаем колко често трябва да се поставя ваксина, за да се предотврати инфекция", обяснява канадският експерт Игор Стагляр, професор по биохимия и молекулярна генетика в университета на Торонто. Той е ръководител на проучването.
"За да отговорим на тези въпроси, имаме нужда от бързи, евтини и количествени тестове, които конкретно измерват нивото на неутрализиращите вируса SARS-CoV-2 антитела - тези, които предотвратяват заразата".
В изследването участва и Шон Оуен, доцент по фармация и фармацевтична химия в университета на щата Юта. Чрез нов метод разработеният тест показва способността на шиповидния протеин на вируса да се свързва с рецептора ACE2, чрез който заразата навлиза в клетките. В последните две години бяха разработени много подобни тестове, но малко от тях са за неутрализиращите антитела, които пречат на разпространението на вируса.
"Нашият метод, който нарекохме Neu-SATiN, е много точен, бърз и евтин..., и може за кратко време да се адаптира към нови варианти, когато те се появят", обяснява Игор Стагляр. Учените са приложили Neu-SATiN при кръвни проби, събрани от 63 пациенти с различна тежест на преболедуване на Ковид-19 и ваксинация до ноември 2021 г. Неутрализиращата способност е оценена спрямо оригиналния ухански щам и разновидностите Алфа, Бета, Гама, Делта и Омикрон.
"Смятахме, че е важно да наблюдаваме хората, които са били ваксинирани, за да установим дали все още имат защита и колко дълго продължава тя", казва Оуен. "Искахме също да проследим дали имунизацията срещу един вариант осигурява защита и срещу дру".
Установено е, че неутрализиращите антитела съществуват около три-четири месеца, след което нивата им спадат с около 70 процента, независимо от преболедуването или от ваксинационния статус. При хибридния имунитет, придобит както чрез преболедуване, така и чрез ваксинация, нивото на антителата е по-високо в началото, но също намаляват значително четири месеца по-късно.
Най-тревожното е, че инфекцията и/или ваксинацията осигуряваха добра защита срещу предишните варианти, но не и срещу Омикрон или неговите подварианти BA.4 и BA.5, отбелязват експертите.
"Важно е да се подчертае, че ваксините все още осигуряват значителна защита от тежко заболяване и смърт", каза Стагляр. Все пак той и колегите му призовават за бдителност, тъй като по-лесно разпространяващите се подварианти BA.4 и BA.5 могат да заобикалят имунитета, придобит от по-ранни инфекции с разновидността Омикрон.
"В близко бъдеще със сигурност ще има нови варианти", каза Стагляр. "Наблюдаването и повишаването на имунитета към циркулиращите варианти ще стават все по-важни и нашият метод може да играе ключова роля в това, тъй като е бърз, точен, количествен и евтин".
Изследователите очакват, че разработеният тест за антитела ще се превърне в ценен инструмент при взимането на решения кой се нуждае от подсилваща доза ваксина и кога. Това ще помогне за спасяването на животи и избягване на въвеждането на сериозни ограничения, е мнението на експертите.
Учените от Канада и САЩ са описали разработката си в изданието "Нейчър комюникейшънс".
"Истината е, че все още не знаем колко често трябва да се поставя ваксина, за да се предотврати инфекция", обяснява канадският експерт Игор Стагляр, професор по биохимия и молекулярна генетика в университета на Торонто. Той е ръководител на проучването.
"За да отговорим на тези въпроси, имаме нужда от бързи, евтини и количествени тестове, които конкретно измерват нивото на неутрализиращите вируса SARS-CoV-2 антитела - тези, които предотвратяват заразата".
В изследването участва и Шон Оуен, доцент по фармация и фармацевтична химия в университета на щата Юта. Чрез нов метод разработеният тест показва способността на шиповидния протеин на вируса да се свързва с рецептора ACE2, чрез който заразата навлиза в клетките. В последните две години бяха разработени много подобни тестове, но малко от тях са за неутрализиращите антитела, които пречат на разпространението на вируса.
"Нашият метод, който нарекохме Neu-SATiN, е много точен, бърз и евтин..., и може за кратко време да се адаптира към нови варианти, когато те се появят", обяснява Игор Стагляр. Учените са приложили Neu-SATiN при кръвни проби, събрани от 63 пациенти с различна тежест на преболедуване на Ковид-19 и ваксинация до ноември 2021 г. Неутрализиращата способност е оценена спрямо оригиналния ухански щам и разновидностите Алфа, Бета, Гама, Делта и Омикрон.
"Смятахме, че е важно да наблюдаваме хората, които са били ваксинирани, за да установим дали все още имат защита и колко дълго продължава тя", казва Оуен. "Искахме също да проследим дали имунизацията срещу един вариант осигурява защита и срещу дру".
Установено е, че неутрализиращите антитела съществуват около три-четири месеца, след което нивата им спадат с около 70 процента, независимо от преболедуването или от ваксинационния статус. При хибридния имунитет, придобит както чрез преболедуване, така и чрез ваксинация, нивото на антителата е по-високо в началото, но също намаляват значително четири месеца по-късно.
Най-тревожното е, че инфекцията и/или ваксинацията осигуряваха добра защита срещу предишните варианти, но не и срещу Омикрон или неговите подварианти BA.4 и BA.5, отбелязват експертите.
"Важно е да се подчертае, че ваксините все още осигуряват значителна защита от тежко заболяване и смърт", каза Стагляр. Все пак той и колегите му призовават за бдителност, тъй като по-лесно разпространяващите се подварианти BA.4 и BA.5 могат да заобикалят имунитета, придобит от по-ранни инфекции с разновидността Омикрон.
"В близко бъдеще със сигурност ще има нови варианти", каза Стагляр. "Наблюдаването и повишаването на имунитета към циркулиращите варианти ще стават все по-важни и нашият метод може да играе ключова роля в това, тъй като е бърз, точен, количествен и евтин".
Изследователите очакват, че разработеният тест за антитела ще се превърне в ценен инструмент при взимането на решения кой се нуждае от подсилваща доза ваксина и кога. Това ще помогне за спасяването на животи и избягване на въвеждането на сериозни ограничения, е мнението на експертите.
Учените от Канада и САЩ са описали разработката си в изданието "Нейчър комюникейшънс".

Comments
comments powered by Disqus